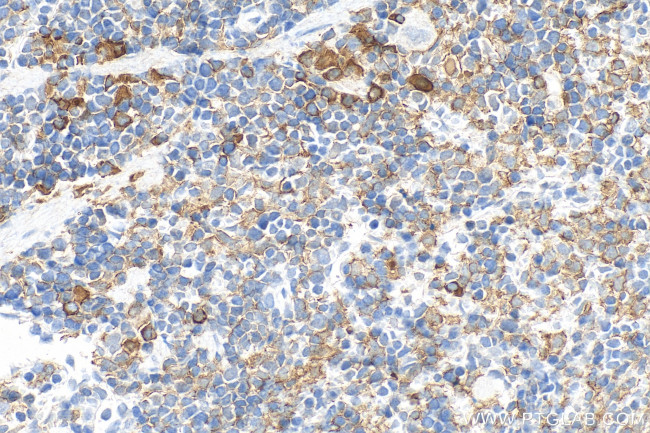
IBA1 Antibody in Immunohistochemistry (Paraffin) (IHC (P))

Search
Proteintech
IBA1 Polyclonal Antibody
{{$productOrderCtrl.translations['antibody.pdp.commerceCard.promotion.promotions']}}
{{$productOrderCtrl.translations['antibody.pdp.commerceCard.promotion.viewpromo']}}
{{$productOrderCtrl.translations['antibody.pdp.commerceCard.promotion.promocode']}}: {{promo.promoCode}} {{promo.promoTitle}} {{promo.promoDescription}}. {{$productOrderCtrl.translations['antibody.pdp.commerceCard.promotion.learnmore']}}
产品信息
30523-1-AP
种属反应
宿主/亚型
分类
类型
抗原
偶联物
形式
浓度
规格
纯化类型
保存液
内含物
保存条件
运输条件
产品详细信息
Immunogen sequence: LKRLIREVSS GSEETFSYSD FLRMMLGKRS AILRMILMYE EKNKEHKRPT GPPAKKAISE LP
靶标信息
Ionized calcium-binding adapter molecule 1 (IBA1), also known by its gene name AIF1, is a protein expressed predominantly by microglia in the brain and spinal cord. This protein belongs to the EF-hand calcium-binding protein family and plays a crucial role in microglial activation and migration in response to brain injury or neuroinflammation. IBA1's function is integral to microglial motility and phagocytic activity, facilitating the cellular response to pathogenic stimuli and promoting tissue homeostasis and repair in the central nervous system. IBA1 serves as a reliable marker for activated microglia in various neurological disorders, including Alzheimer's disease, Parkinson's disease, and multiple sclerosis, where increased expression correlates with disease progression and severity. The protein's structural features enable it to bind calcium ions, inducing conformational changes that activate signaling pathways essential for microglial function. Its expression is highly regulated by inflammatory cytokines, underpinning its role in neuroimmune responses. Due to its specific expression in microglia during pathological conditions, IBA1 is widely used in research as a marker to study microglial status and activity, and it remains a focal point for understanding microglial involvement in neurodegenerative diseases.
仅用于科研。不用于诊断过程。未经明确授权不得转售。
篇参考文献 (0)
生物信息学
蛋白别名: AIF-1; Allograft inflammatory factor 1; balloon angioplasty responsive transcript; balloon angioplasty-responsive transcript 1; DADB-70P7.8; DASS-82G15.2; Em:AF129756.17; Iba; ionized calcium binding adapter molecule 1; Ionized calcium-binding adapter molecule 1; Microglia response factor; MRF-1; protein BART-1; testis specific
基因别名: AI607846; AIF-1; Aif1; BART-1; Bart1; D17H6S50E; G1; Iba1; mrf-1; Mrf1
UniProt ID: (Mouse) O70200, (Rat) P55009
Entrez Gene ID: (Mouse) 11629, (Rat) 29427